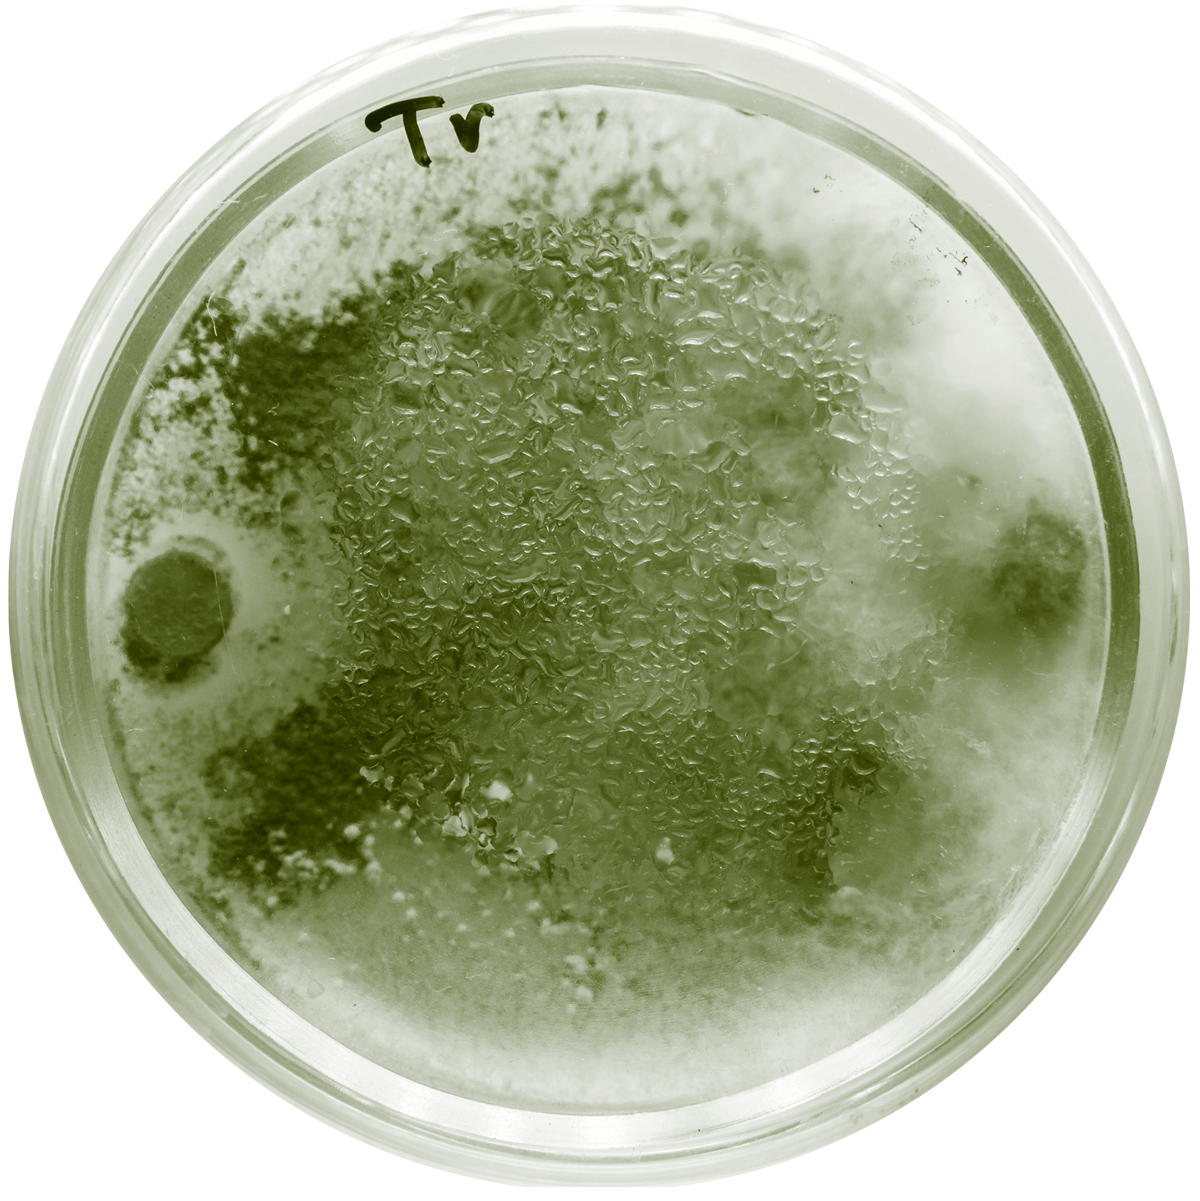
trichoderma-soil-microbe

How to improve soil health?
How natural biostimulants are shaping the future of farming

Soil erosion and degradation are among the most pressing environmental challenges globally. In South Africa alone, an estimated 10%-20% of agricultural land is affected to varying degrees, and roughly 12 million hectares are considered severely eroded. More broadly, studies suggest that up to 60% of national land is degraded in some form, undermining water security, biodiversity, and the long-term productivity on which farmers depend.
Healthy soils are the foundation not only of agricultural productivity but also of rural livelihoods, food systems, and trade. Even though agriculture contributes a relatively small percentage to national GDP in many countries, its impact extends far beyond production – supporting communities, agro-processing, and global food security.
World Soil Day, observed globally on 5 December, draws attention to the essential role of soil in human wellbeing. Established by the International Union of Soil Sciences, endorsed by the FAO, and recognised by the UN General Assembly, the day anchors an international campaign urging better soil stewardship.
Restoring soil function is essential for climate resilience and sustainable agriculture worldwide. Many farmers are adopting regenerative practices that improve plant–soil interactions over time. Among these tools are natural biostimulants derived from seaweed, which have been studied for their compatibility with beneficial soil microbes and their potential to support root development, stress tolerance and crop establishment when used alongside good agronomy.
Laboratory work on extracts of Ecklonia maxima, the South African kelp species used in Kelpak’s natural biostimulants, has shown promising results. In controlled trials, beneficial organisms such as Trichoderma (a fungus that protects roots against harmful pathogens) and rhizobia (nitrogen-fixing bacteria) showed their strongest viability when exposed to low concentrations of the extracts for short periods. This suggests that natural extracts can work in harmony with microbial inoculants under the right conditions.
A separate Polish study by Kelpak on Trichoderma harzianum and Verticillium dahliae found that while the extract supported the growth of beneficial fungi, it simultaneously slowed the sporulation of harmful pathogens. This is an example of the selective effects that impact the soil microbiome.
“World Soil Day is a reminder that agro-ecosystems start with living soil,” says Linda Greyling, Head of Technical Support at Kelpak. “Biostimulants are not a silver bullet. They are most effective when used together with sound practices such as mulching, diversified rotations and careful traffic management. Our focus is on generating practical evidence that helps farmers apply natural tools where they make agronomic sense, season after season.”
Long-term benefits associated with Kelpak include:
- Supporting beneficial microbes such as Trichoderma and rhizobia to survive and remain active.
- Promoting the growth of beneficial fungi while slowing certain disease-causing species.
- Improving plant-level tolerance to abiotic stress such as heat or drought alongside other beneficial practices
- Being used effectively alongside seed treatments or inoculants when applied according to guidance.
Healthy soils are living, dynamic systems, and safeguarding them is essential for resilient agriculture worldwide. By integrating natural biostimulants thoughtfully with regenerative practices, farmers can rebuild soil function, enhance crop resilience, and take meaningful steps toward a sustainable agricultural future rooted in living soil.”
About Linda Greyling:
Linda Greyling is the Head of Technical Support at Kelpak®, where she leads the company’s global technical initiatives, crop trials, and support programmes. Based in Johannesburg, she serves as the technical link between Kelpak’s regional teams, marketing, customer support, and research and development. With over 30 years of experience working with South Africa’s leading agricultural partners, Linda has built expansive expertise across multiple agricultural disciplines.
Kelpak support
For more information on how Kelpak can improve crop health, resilience and marketable yields or for nearest distributor information, please contact one of the phone numbers or email addresses below:
KELP PRODUCTS INTERNATIONAL
Head Office - South Africa
Tel: +27 21 786 2090
Fax: +27 21 786 3274
Email: info@kelpak.com
TECHNICAL SUPPORT
Contact: Linda Greyling
Email: linda.greyling@kelpak.com
or
Paul Hills
Email: paul.hills@kelpak.com
To process your enquiry efficiently please complete all fields:



